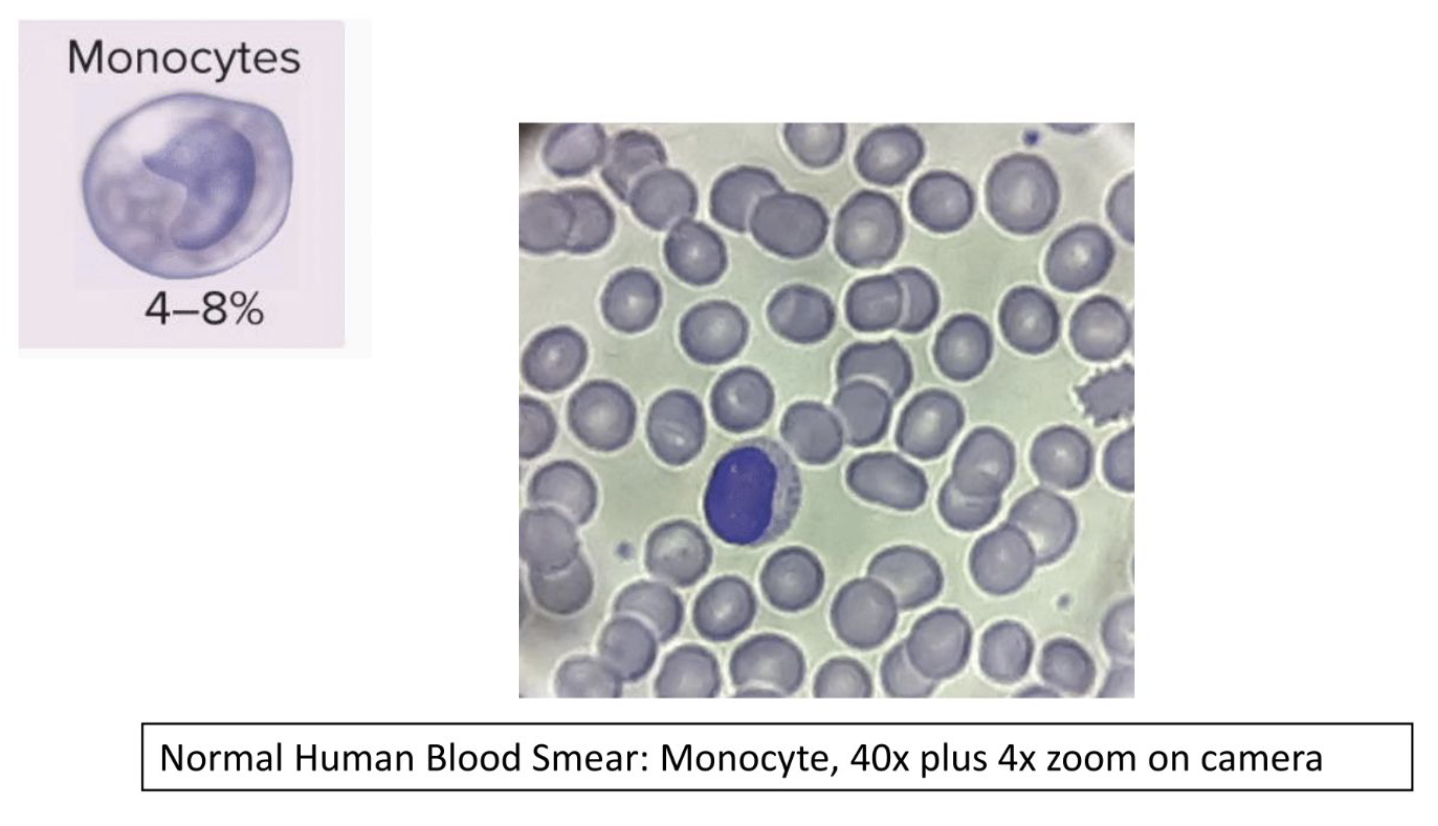
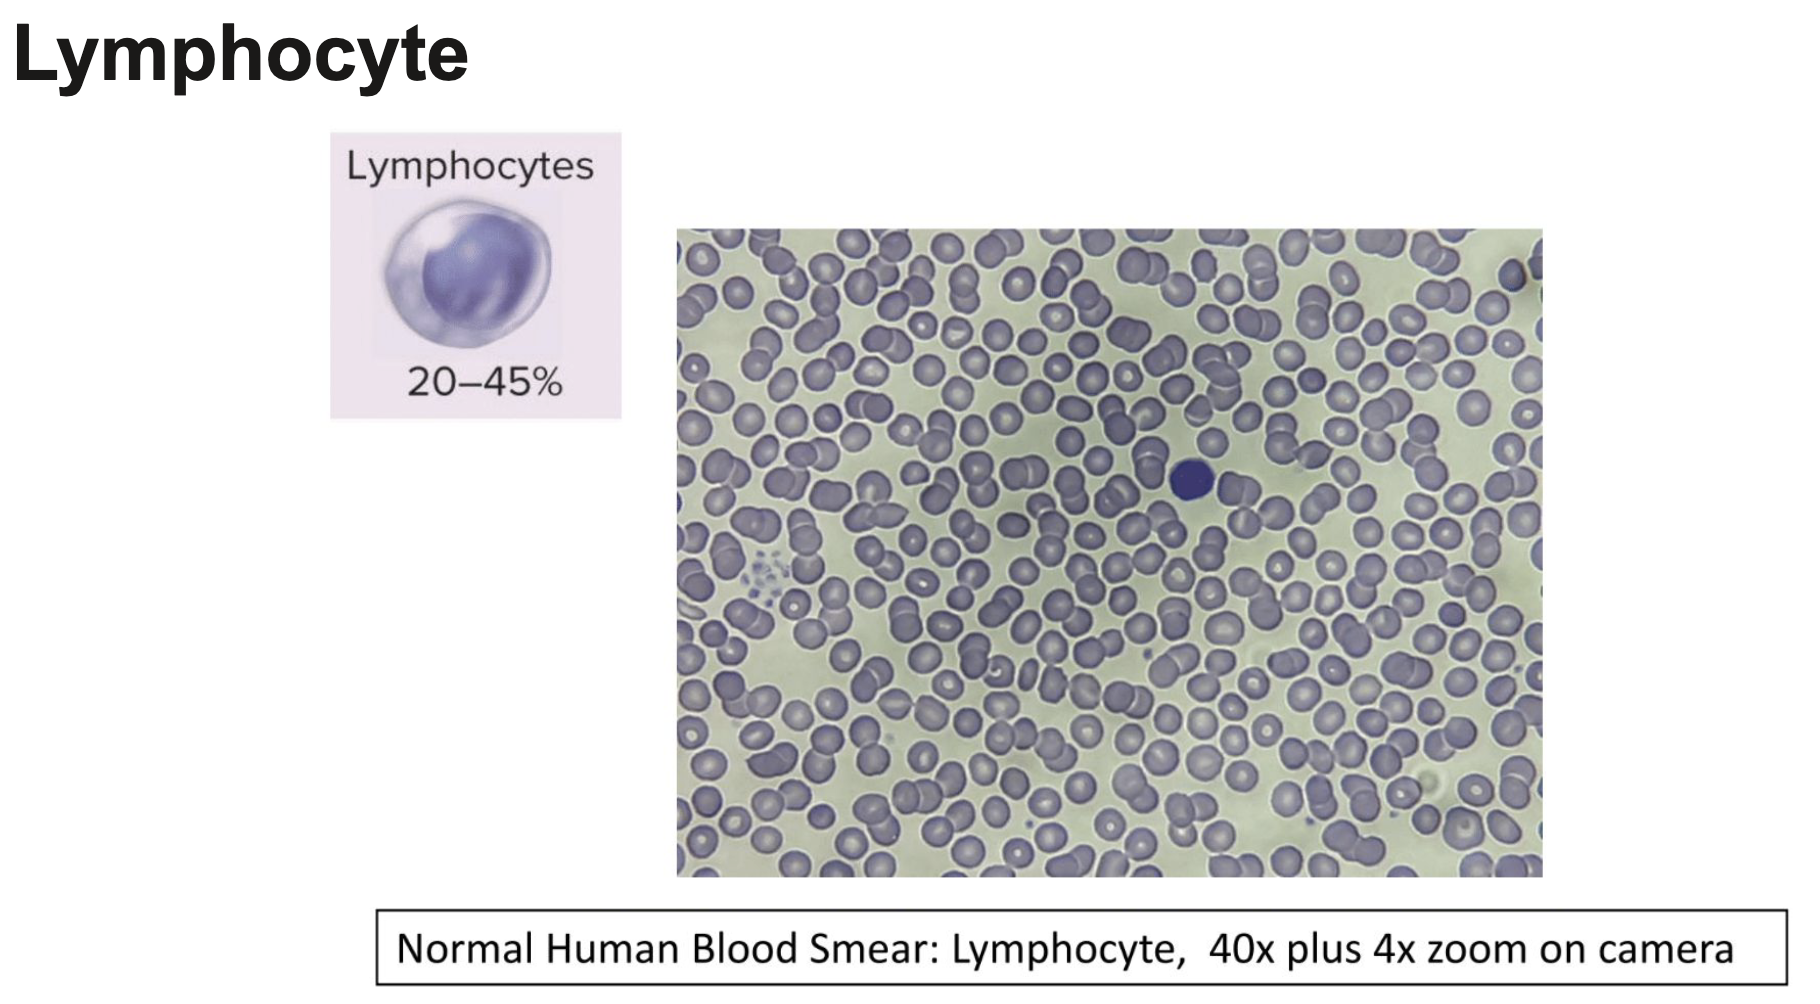
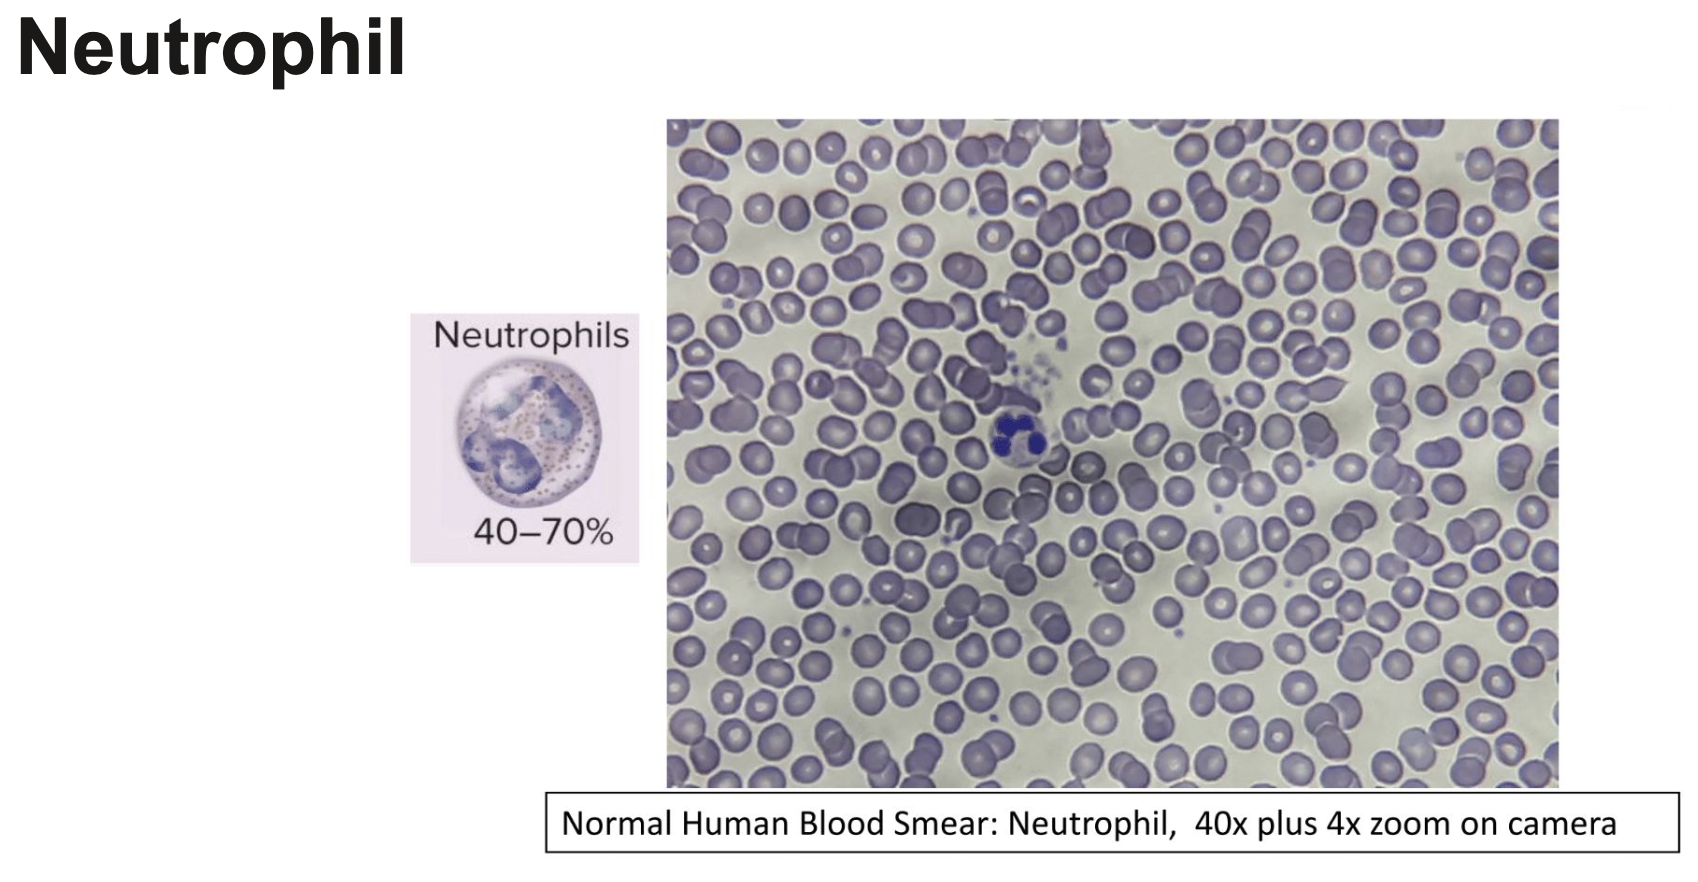
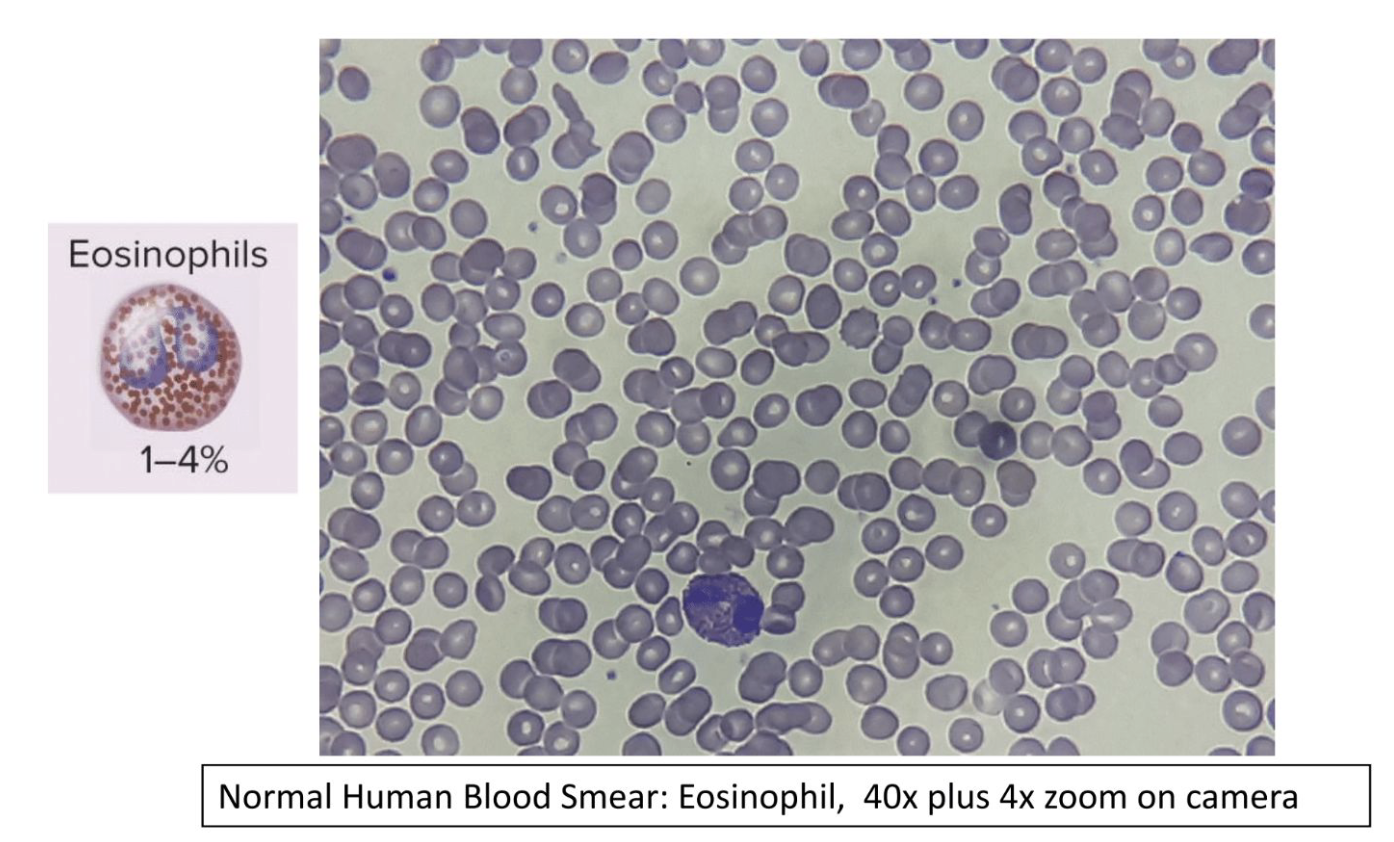
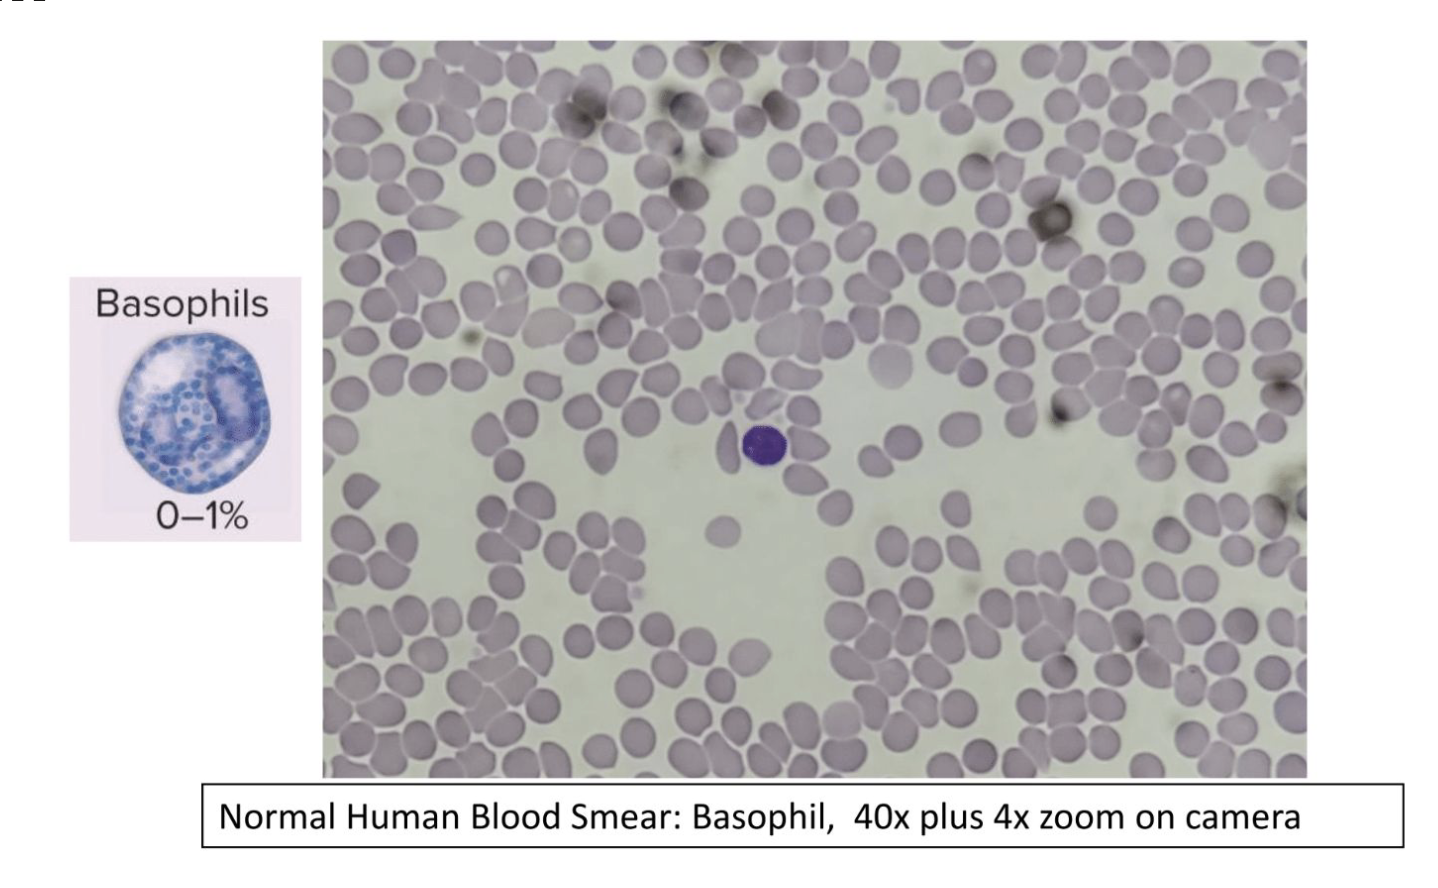

Bio Lab 8: Blood experiment, Blood Typing and Immune System Cells + Lab 39 Endocrine System
1/38
There's no tags or description
Looks like no tags are added yet.
Name | Mastery | Learn | Test | Matching | Spaced | Call with Kai |
|---|
No analytics yet
Send a link to your students to track their progress
39 Terms
What is Blood?
a type of tissue with several components
RBCs transport oxygen throughout the body
WBSc help fight off infections
Plasma = matrix
Platelets = help blood clot
Pathogen
a foreign microorganism of bacteria that can cause disease
Phagocytosis
ingestion of bacteria or other material
WBS
neutrophils
eosinophils
basophils
lymphocytes
monocytes
Agranulocytes
no granules that get stained during WBC counting
nucleus is very visible
monocyte and lymphocyte
Monocytes
4-8%
bean shaped
can become macrophages which phagocytose pathogens and cell debris
Lymphocytes
can become B and T cells which are immune cells and are part of your adaptive immunity
20-45%
Granulocytes
have granules that get stained during WBC counting
nucleus can be hard to see
2nd line of defense: Neutrophils
neutrophil, eosinophil, basophil
Neutrophil
40 - 70%
hunt pathogens and phagocytose them
most abundant wbc
Eosinophil
2 lobes with specks
1-4%
phagocytosis antigen - antibody complexes, allergens, and target parasites
Basophil
0-1%
release histamines to help blood flow and recruit immune cells to the site of the infection
Blood Typing: Understanding A, B, and O
Blood Typing Understanding Rh Factor
Rh factor is another antigen to look for on red blood cells
makes the blood + or -
Rh antigen on RBC’s: +
Rh antigen not on RBC’s: -
Agglutination
happens when you give someone blood that contains antibodies for their blood
The Endocrine System
consists of glands and tissues that secrete hormones
secrete hormones directly into blood for distribution throughout the body
endocrine and nervous system are intimately involved in maintaining homeostasis
hormones can be lipid steroids or a mixture of protein / sugar / amino acid complexes
Hypothalamus controls
the pituitary gland
hypothalamus = part of the brain that helps to regulate the internal environment, it receives info on the heart beat and body temp
to do this it controls the secretions of the pituitary gland
The Pituitary Gland has 2 parts
Pituitary gland = connected to the brain by the stalk and has 2 parts
anterior pituitary (secretes hormones to regulate other glands)
posterior pituitary (stores other hormones and secretes them when needed)
Anterior Pituitary
controls the secretion of the following endocrine glands:
thyroid gland
adrenal
cortex
gonads
Posterior Pituitary
stores hormones from the hypothalamus
DOES NOT produce hormones but stores and secretes the hormones produced by the hypothalamus
Hypothalamus makes 2 hormones:
Antidiuretic hormone (ADH)
Water retention by kidneys to help prevent dehydration
Oxytocin
emotional bonding, labor contractions, etc.
Thyroid Gland
produces 2 iodine dependent hormones and one hormone involved in calcium homeostasis
Triiodothyronine (T3 hormones)
Thyroxine (T4) hormones
Calcitonin hormone
lowers blood calcium levels
Thyroid hormones do not have a single specific target
stimulate all cells of the body to metabolize faster
AKA thyroid hormones can increase metabolic rate
Response to Cold
Low body temp can be regulated through increasing metabolic rate and by shivering
if an organism cannot regulate its temp through metabolic rate, it will rely on shivering → requires more oxygen
primary effect of the thyroid hormone is to promote heat generating metabolic reactions
Parathyroid Gland
produces parathyroid hormone (PTH)
increases blood calcium level
also promotes reabsorption of calcium by the kidneys
activates vitamin D to stimulate calcium from intestine
Adrenal Gland (Cortex and Medulla)
Adrenal Glands sit atop the kidney
each gland has an adrenal cortex and a medulla
Hypothalamus exerts control over
adrenal medulla: controlled by nerve
impulses from the brain to control fight or
flight hormones
Epinephrine and norepinephrine
adrenal cortex: controlled by hormones
from the hypothalamus to control
salt/water balance, metabolism of
macromolecules, and a little bit of sex
hormonesaldosterone, cortisol
Pancreas
Composed of two types of tissue
○ Exocrine tissue produces digestive juices that pass through ducts to the small intestine.
○ Endocrine tissue (pancreatic islets) produces and secretes insulin and glucagon directly into the blood
Insulin
lowers blood glucose
stimulates uptake of glucose by cells — especially liver (turns glucose to glycogen remember!), muscle, and adipose tissue cells
Glucagon
Raises blood glucose
○ Stimulates liver to break down glycogen to glucose and to use fat and protein instead of glucose as an energy source
VL 17 Thyroid Hormone and Temp